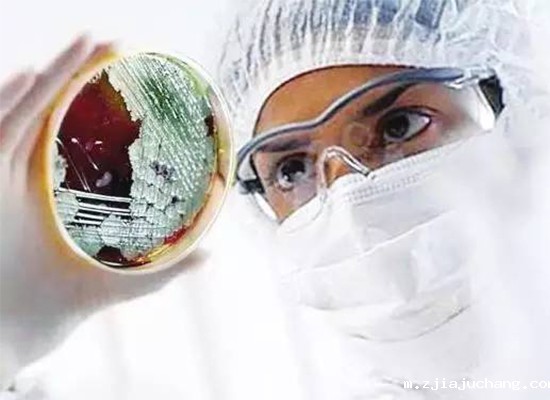
新冠疫情持续燃烧，更多医疗实验机构启用全自动菲尔特华体会

LABORATORY
欢 “洗” 实验室
NEWS AND TRENDS
华体会体育最新地址

石油化工行业的设备清洗(如反应釜、换热器、储罐、管道等)是保障生产安全、维持设备效率的必要环节,但传统清洗过程常伴随高能耗、高水耗、高化学污染及低效运行等问题。随着“双碳”目标的推进与绿色制造理念的深...
VIEW <<
一:实验室菲尔特华体会的特点:1、更大容积的冷凝器有效杜绝在实验室内排放蒸汽而造成的隐患。2、空气加热器,大容积冷凝器,过滤器和高效风机组成的高效烘干系统,在循环加热,吹汽,冷凝,排放的过程中快速,洁净地烘干器皿。3、两点式门...
VIEW <<
同手工操作洗瓶相比,菲尔特华体会无论是在洗瓶的质量上还是工作效率方面,已达到了较为成熟的水平。如今,在玻璃瓶、塑料瓶等食品饮料加工行业得到较为广泛的应用。随着市场规模的逐步扩大和技术水平的不断提高,菲尔特华体会的高效性、...
VIEW <<
菲尔特华体会是当下实验室中的“网红”产品。为实验室工作人员提供了许多方便,省去了大量的手动清洗工作,更重要的是保障了操作者免受残留化学品的侵蚀。日常的维护保养对机器的清洗效果和机器的使用寿命有着很重要的意义,而故...
VIEW <<
还记得刚进实验室做的第一件事是什么吗?在实验室里做的第一件事就是刷瓶子,而且刷了好久,一度怀疑我是不是来错地方了,或许去饭店刷碗可能能把饭店老板刷破产的那种水平。后来我总算明白了,原来刷瓶子就是实验室(拜码头)的考...
VIEW <<
爆发于2020年开春的疾病疫情如黑云压顶,为全人类的健康都带来威胁。这场由新冠病毒所形成的疫情延烧至今已造成了全球超过600多万人感染,30几万人为此而丧生,而且不少专家对疫情在短期彻底结束极不乐观。如果说疾病是全...
VIEW <<